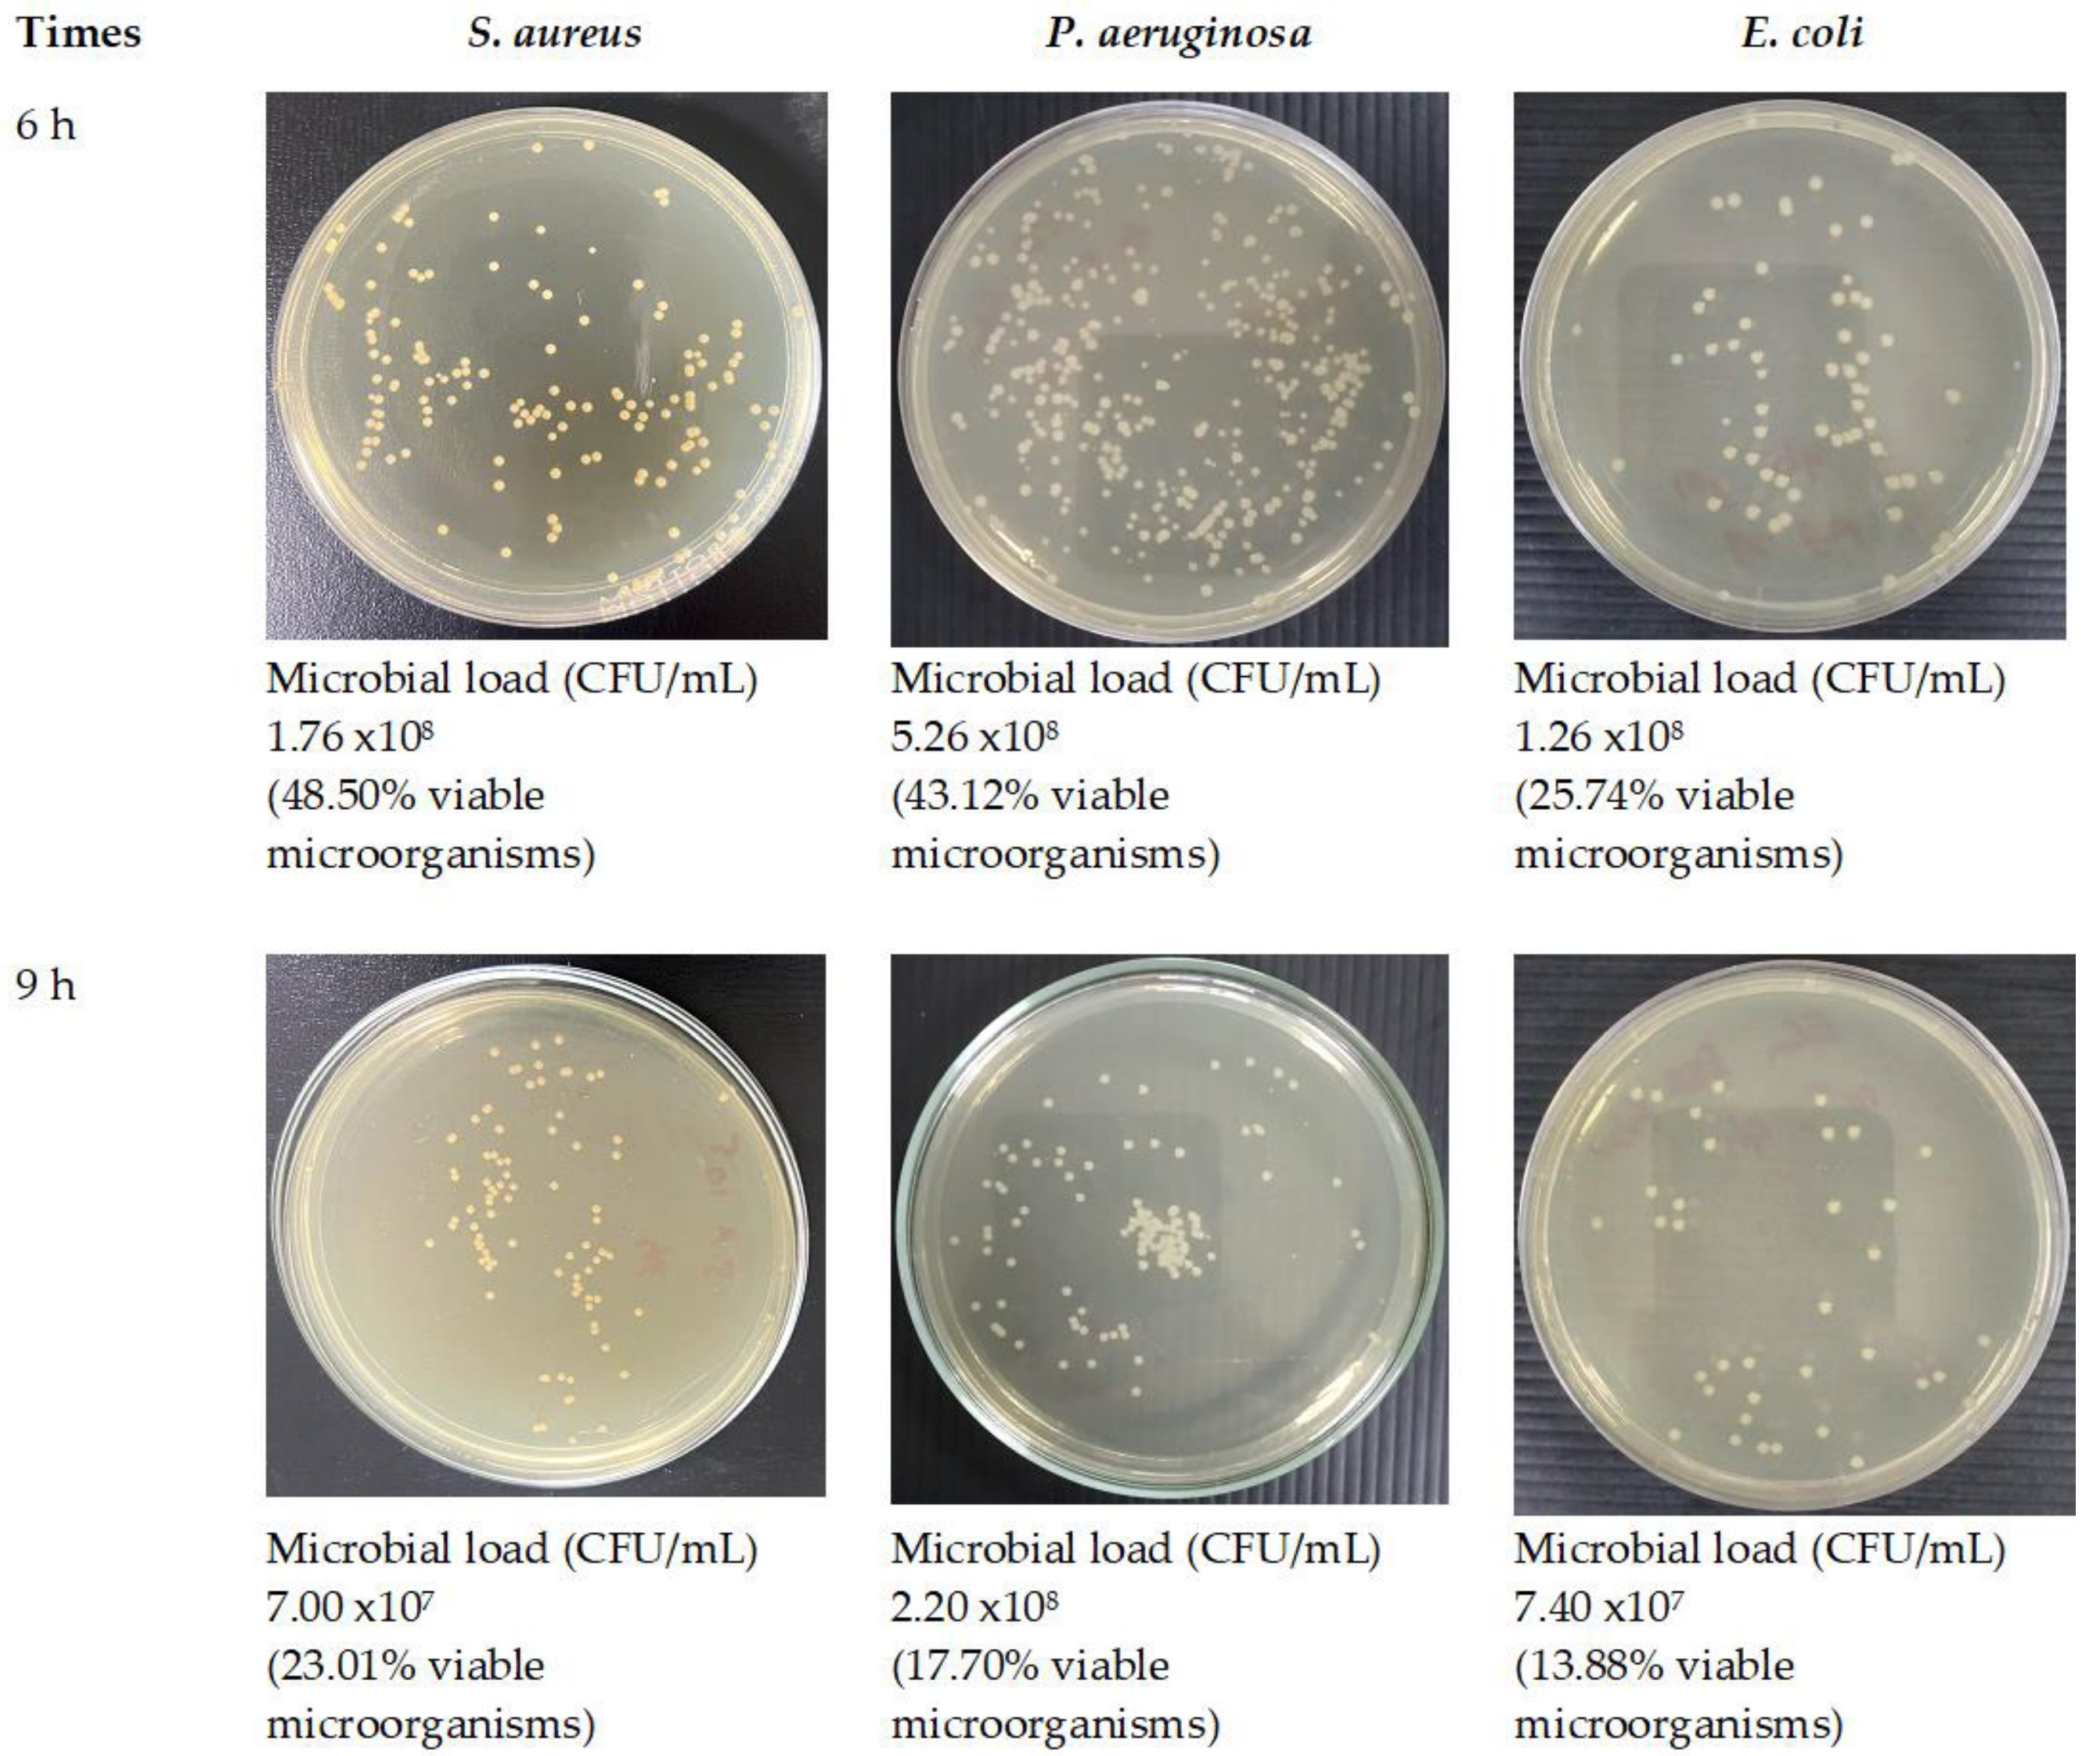
Polymers 16 00183 g016b

Fabrication and Optimization of Electrospun Shellac Fibers Loaded with Senna alata Leaf Extract
Abstract
1. Introduction
2. Materials and Methods
2.1. Materials
2.2. Preparation and Phytochemical Analysis of SA Leaf Extract
2.3. Design of Experiments
2.3.1. Fractional Factorial Design (FFD)
2.3.2. Box–Behnken Design (BBD)
2.4. Preparation and Evaluation of Shellac-SA Leaf Extract Solutions
2.5. Fabrication of Electrospun Shellac Fibers Loaded with SA Leaf Extract
2.6. Entrapment Efficiency of SA Leaf Extract into Electrospun Fibers
2.7. In Vitro Release Study
2.8. Release Kinetics
2.9. Characterization of Electrospun Shellac Fibers Loaded with SA Leaf Extract
2.9.1. Scanning Electron Microscope (SEM)
2.9.2. Powder X-ray Diffraction (PXRD)
2.9.3. Differential Scanning Calorimetry (DSC)
2.9.4. Fourier Transform Infrared (FTIR) Spectroscopy
2.10. Antimicrobial Activity of Optimized Fibers
3. Results
3.1. Extraction and Phytochemical Analysis of SA Leaf Extract
3.2. Design of Experiments
3.2.1. Fractional Factorial Design (FFD)
3.2.2. Box–Behnken Design (BBD)
3.3. Evaluation of Solution Properties
3.4. Entrapment Efficiency of Electrospun Shellac Fibers Loaded with SA Leaf Extract
3.5. In Vitro Release Study
3.6. Release Kinetics
3.7. Characterization of Electrospun Shellac Fibers Loaded with SA Leaf Extract
3.7.1. Scanning Electron Microscope (SEM)
3.7.2. Powder X-ray Diffraction (PXRD)
3.7.3. Differential Scanning Calorimetry (DSC)
3.7.4. Fourier Transform Infrared (FTIR) Spectroscopy
3.8. Antimicrobial Activity of Optimized Fibers
4. Discussion
5. Conclusions
Author Contributions
Funding
Institutional Review Board Statement
Data Availability Statement
Acknowledgments
Conflicts of Interest
References
- Oladeji, O.S.; Adelowo, F.E.; Oluyori, A.P.; Bankole, D.T. Ethnobotanical description and biological activities of Senna alata. Evid. Based Complement. Alternat. Med. 2020, 2020, 2580259. [Google Scholar] [CrossRef] [PubMed]
- Grosvenor, P.W.; Gothard, P.K.; McWilliam, N.C.; Supriono, A.; Gray, D.O. Medicinal plants from Riau Province, Sumatra, Indonesia. Part 1: Uses. J. Ethnopharmacol. 1995, 45, 75–95. [Google Scholar] [CrossRef] [PubMed]
- Palanichamy, S.; Nagarajan, S. Analgesic activity of Cassia alata leaf extract and kaempferol 3-O-sophoroside. J. Ethnopharmacol. 1990, 29, 73–78. [Google Scholar] [CrossRef]
- Elujoba, A.A.; Ajulo, O.O.; Iweibo, G.O. Chemical and biological analyses of Nigerian Cassia species for laxative activity. J. Pharm. Biomed. Anal. 1989, 7, 1453–1457. [Google Scholar] [CrossRef]
- Sagnia, B.; Fedeli, D.; Casetti, R.; Montesano, C.; Falcioni, G.; Colizzi, V. Antioxidant and anti-inflammatory activities of extracts from Cassia alata, Eleusine indica, Eremomastax speciosa, Carica papaya and Polyscias fulva medicinal plants collected in Cameroon. PLoS ONE 2014, 9, e103999. [Google Scholar] [CrossRef]
- Somchit, M.; Reezal, I.; Nur, I.E.; Mutalib, A. In Vitro antimicrobial activity of ethanol and water extracts of Cassia alata. J. Ethnopharmacol. 2003, 84, 1–4. [Google Scholar] [CrossRef]
- Kasiama, G.N.; Ikey, A.; Kabengele, C.N.; Kilembe, J.T.; Matshimba, E.N.; Bete, J.M. Anthelmintic and antioxidant activities, phytochemical profile and microscopic features of Senna alata collected in the Democratic Republic of Congo. Annu. Res. Rev. Biol. 2022, 37, 28–36. [Google Scholar] [CrossRef]
- Karthika, C.; Mohamed, R.K.; Manivannan, S. Phytochemical analysis and evaluation of antimicrobial potential of Senna alata Linn. leaves extract. Asian J. Pharm. Clin. Res. 2016, 9, 253–257. [Google Scholar]
- Ahmed, S.; Shohael, A.M. In silico studies of four anthraquinones of Senna alata L. as potential antifungal compounds. Pharmacologyonline 2019, 2, 259–268. [Google Scholar]
- Khare, C.P. Indian Medicinal Plants; Springer Press: London, UK, 2007; pp. 126–127. [Google Scholar]
- Aung, W.W.; Panich, K.; Watthanophas, S.; Naridsirikul, S.; Ponphaiboon, J.; Krongrawa, W.; Kulpicheswanich, P.; Limmatvapirat, S.; Limmatvapirat, C. Preparation of bioactive de-chlorophyll rhein-rich Senna alata extract. Antiobotics 2023, 12, 181. [Google Scholar] [CrossRef]
- Limmatvapirat, S.; Limmatvapirat, C.; Luangtana-anan, M.; Nunthanid, J.; Oguchi, T.; Tozuka, Y.; Yamamoto, K.; Puttipipatkhachorn, S. Modification of physicochemical and mechanical properties of shellac by partial hydrolysis. Int. J. Pharm. 2004, 278, 41–49. [Google Scholar] [CrossRef] [PubMed]
- Goswami, D.N.; Saha, S.K. An investigation of the melting properties of different forms of lac by differential scanning calorimeter. Surf. Coat. Int. 2000, 83, 334–336. [Google Scholar] [CrossRef]
- Thombare, N.; Kumar, S.; Kumari, U.; Sakare, P.; Yogi, R.K.; Prasad, N.; Sharma, K.K. Shellac as a multifunctional biopolymer: A review on properties, applications and future potential. Int. J. Biol. Macromol. 2022, 215, 203–223. [Google Scholar] [CrossRef]
- Yuan, Y.; He, N.; Dong, L.; Guo, Q.; Zhang, X.; Li, B.; Li, L. Multiscale shellac-based delivery systems: From macro- to nanoscale. ACS Nano 2021, 15, 18794–18821. [Google Scholar] [CrossRef]
- Pandey, S.K.; Yadav, S.K.S.; Prasad, N.; Sharma, S.C. Chouri-parta method of estimating seedlac yield. J. AgriSearch. 2018, 5, 260–264. [Google Scholar] [CrossRef]
- Saengsod, S.; Limmatvapirat, S.; Luangtana-Anan, M. A new approach for the preparation of bleached shellac for pharmaceutical application: Solid method. Adv. Mater. Res. 2012, 506, 250–253. [Google Scholar] [CrossRef]
- Luangtana-Anan, M.; Saengsod, S.; Limmatvapirat, S. Improvement of bleached shellac as enteric coating by composite formation. AAPS PharmSciTech. 2021, 22, 241. [Google Scholar] [CrossRef]
- Chauhan, O.P.; Nanjappa, C.; Ashok, N.; Ravi, N.; Roopa, N.; Raju, P.S. Shellac and Aloe vera gel based surface coating for shelf life extension of tomatoes. J. Food Sci. Technol. 2013, 52, 1200–1205. [Google Scholar] [CrossRef]
- Chuenbarn, T.; Tuntarawongsa, S.; Janmahasatian, S.; Phaechamud, T. Bleached shellac in situ forming micro-particle fabricated with different oils as antibacterial delivery system for periodontitis treatment. Mater. Today Proc. 2021, 47, 3546–3553. [Google Scholar] [CrossRef]
- Senarat, S.; Wai Lwin, W.; Mahadlek, J.; Phaechamud, T. Doxycycline hyclate-loaded in situ forming gels composed from bleached shellac, Ethocel, and Eudragit RS for periodontal pocket delivery. Saudi Pharm. J. 2021, 29, 252–263. [Google Scholar] [CrossRef]
- Patra, J.K.; Das, G.; Fraceto, L.F.; Campos, E.V.R.; Rodriguez-Torres, M.d.P.; Acosta-Torres, L.S.; Diaz-Torres, L.A.; Grillo, R.; Swamy, M.K.; Sharma, S.; et al. Nano based drug delivery systems: Recent developments and future prospects. J. Nanobiotechnol. 2018, 16, 71. [Google Scholar] [CrossRef] [PubMed]
- Chinatangkul, N.; Limmatvapirat, C.; Nunthanid, J.; Luangtana-Anan, M.; Sriamornsak, P.; Limmatvapirat, S. Design and characterization of monolaurin loaded electrospun shellac nanofibers with antimicrobial activity. Asian J. Pharm. Sci. 2018, 13, 459–471. [Google Scholar] [CrossRef] [PubMed]
- Huang, J.; Deng, Y.; Ren, J.; Chen, G.; Wang, G.; Wang, F.; Wu, X. Novel in situ forming hydrogel based on xanthan and chitosan re-gelifying in liquids for local drug delivery. Carbohydr. Polym. 2018, 186, 54–63. [Google Scholar] [CrossRef] [PubMed]
- Sun, B.; Zhang, M.; Shen, J.; He, Z.; Fatehi, P.; Ni, Y. Applications of cellulose-based materials in sustained drug delivery systems. Curr. Med. Chem. 2019, 26, 2485–2501. [Google Scholar] [CrossRef] [PubMed]
- Atanasov, A.G.; Waltenberger, B.; Pferschy-Wenzig, E.-M.; Linder, T.; Wawrosch, C.; Uhrin, P.; Temml, M.; Wang, L.; Schwaiger, S.; Heiss, E.H.; et al. Discovery and resupply of pharmacologically active plant-derived natural products: A review. Biotechnol. Adv. 2015, 33, 1582–1614. [Google Scholar] [CrossRef]
- Utreja, P.; Jain, S.; Tiwary, A.K. Novel drug delivery systems for sustained and targeted delivery of anti-cancer drugs: Current status and future prospects. Curr. Drug Deliv. 2010, 7, 152–161. [Google Scholar] [CrossRef]
- Garg, T.; Rath, G.; Goyal, A.K. Biomaterials-based nanofiber scaffold: Targeted and controlled carrier for cell and drug delivery. J. Drug Target. 2014, 23, 202–221. [Google Scholar] [CrossRef]
- Balogh, A.; Farkas, B.; Faragó, K.; Farkas, A.; Wagner, I.; Assche, I.V.; Verreck, G.; Nagy, Z.K.; Marosi, G. Melt-blown and electrospun drug-loaded polymer fiber mats for dissolution enhancement: A comparative study. J. Pharm. Sci. 2015, 104, 1767–1776. [Google Scholar] [CrossRef]
- Krongrawa, W.; Limmatvapirat, S.; Vollrath, M.K.; Kittakoop, P.; Saibua, S.; Limmatvapirat, C. Fabrication, optimization, and characterization of antibacterial electrospun shellac fibers loaded with Kaempferia parviflora extract. Pharmaceutics 2023, 15, 123. [Google Scholar] [CrossRef]
- Weng, L.; Xie, J. Smart electrospun nanofibers for controlled drug release: Recent advances and new perspectives. Curr. Pharm Des. 2015, 21, 1944–1959. [Google Scholar] [CrossRef]
- Liu, H.; Gough, C.R.; Deng, Q.; Gu, Z.; Wang, F.; Hu, X. Recent advances in electrospun sustainable composites for biomedical, environmental, energy, and packaging applications. Int. J. Mol. Sci. 2020, 21, 4019. [Google Scholar] [CrossRef] [PubMed]
- Gunst, R.F.; Mason, R.L. Fractional factorial design. WIREs Comput. Stat. 2009, 1, 234–244. [Google Scholar] [CrossRef]
- Wagner, J.R.; Mount, E.M.; Giles, H.F. 25—Design of Experiments. In Extrusion, 2nd ed.; Wagner, J.R., Mount, E.M., Giles, H.F., Eds.; William Andrew Publishing: Oxford, UK, 2014; pp. 291–308. [Google Scholar]
- Yuangyai, C.; Nembhard, H.B. Chapter 8—Design of Experiments: A Key to Innovation in Nanotechnology. In Emerging Nanotechnologies for Manufacturing; Ahmed, W., Jackson, M.J., Eds.; William Andrew Publishing: Boston, MA, USA, 2010; pp. 207–234. [Google Scholar]
- Sahoo, P.; Barman, T.K. 5—ANN modelling of fractal dimension in machining. In Mechatronics and Manufacturing Engineering; Davim, J.P., Ed.; Woodhead Publishing: Cambridge, UK, 2012; pp. 159–226. [Google Scholar]
- Das, A.K.; Dewanjee, S. Chapter 3—Optimization of Extraction Using Mathematical Models and Computation. In Computational Phytochemistry; Sarker, S.D., Nahar, L., Eds.; Elsevier: Amsterdam, The Netherlands, 2018; pp. 75–106. [Google Scholar]
- Azimi, B.; Maleki, H.; Zavagna, L.; De la Ossa, J.G.; Linari, S.; Lazzeri, A.; Danti, S. Bio-based electrospun fibers for wound healing. J. Funct. Biomater. 2020, 11, 67. [Google Scholar] [CrossRef] [PubMed]
- Zahedi, E.; Esmaeili, A.; Eslahi, N.; Shokrgozar, M.A.; Simchi, A. Fabrication and characterization of core-shell electrospun fibrous mats containing medicinal herbs for wound healing and skin tissue engineering. Mar. Drugs 2019, 17, 27. [Google Scholar] [CrossRef]
- Mutlu, G.; Calamak, S.; Ulubayram, K.; Guven, E. Curcumin-loaded electrospun PHBV nanofibers as potential wound-dressing material. J. Drug Deliv. Sci. Technol. 2018, 43, 185–193. [Google Scholar] [CrossRef]
- Moradkhannejhad, L.; Abdouss, M.; Nikfarjam, N.; Shahriari, M.H.; Heidary, V. The effect of molecular weight and content of PEG on in vitro drug release of electrospun curcumin loaded PLA/PEG nanofibers. J. Drug Deliv. Sci. Technol. 2020, 56, 101554. [Google Scholar] [CrossRef]
- Yao, C.-H.; Yeh, J.-Y.; Chen, Y.-S.; Li, M.-H.; Huang, C.-H. Wound-healing effect of electrospun gelatin nanofibres containing Centella asiatica extract in a rat model. J. Tissue Eng. Regen. Med. 2015, 11, 905–915. [Google Scholar] [CrossRef]
- Sadri, M.; Arab-Sorkhi, S.; Vatani, H.; Bagheri-Pebdeni, A. New wound dressing polymeric nanofiber containing green tea extract prepared by electrospinning method. Fibers Polym. 2015, 16, 1742–1750. [Google Scholar] [CrossRef]
- Chiu, C.-M.; Nootem, J.; Santiwat, T.; Srisuwannaket, C.; Pratumyot, K.; Lin, W.-C.; Mingvanish, W.; Niamnont, N. Enhanced stability and bioactivity of Curcuma comosa Roxb. extract in electrospun gelatin nanofibers. Fibers 2019, 7, 76. [Google Scholar] [CrossRef]
- Nayak, B.K.; Mukilarasi, V.; Nanda, A. Antibacterial activity of leaf extract of Cassia alata separated by soxhlet extraction method. Der Pharm. Lett. 2015, 7, 254–257. [Google Scholar]
- Muhammad, S.L.; Wada, Y.; Mohammed, M.; Ibrahim, S.; Musa, K.Y.; Olonitola, O.S.; Ahmad, M.H.; Mustapha, S.; Rahman, Z.A.; Sha’aban, A. Bioassay-guided identification of bioactive compounds from Senna alata L. against methicillin-resistant Staphylococcus aureus. Appl. Microbiol. 2021, 1, 520–536. [Google Scholar] [CrossRef]
- Donkor, A.M.; Mosobil, R.; Suurbaar, J. In Vitro bacteriostatic and bactericidal activities of Senna alata, Ricinus communis and Lannea barteri extracts against wound and skin disease causing bacteria. J. Anal. Pharm. Res. 2016, 3, 00046. [Google Scholar] [CrossRef]
- Anibijuwon, I.I.; Gbala, I.D.; Nnadozie, B.I.; Ifayefunmi, O.O. Susceptibility of selected multi-drug resistant clinical isolates to different leaf extracts of Senna alata. Not. Sci. Biol. 2018, 10, 26–32. [Google Scholar] [CrossRef]
- Mordi, R.M.; Osula, A.N.; Igeleke, C.L.; Odjadjare, E.E.; Oboh, F.O.J.; Uwadiae, E.O. The evaluation of the antimicrobial property of Cassia alata leaves in Benin city, Nigeria. Biomed. Nurs. 2016, 2, 14–23. [Google Scholar] [CrossRef]
- He, H.; Kara, Y.; Molnar, K. Effect of needle characteristic on fibrous PEO produced by electrospinning. Resolut. Discov. 2019, 4, 7–11. [Google Scholar] [CrossRef]
- Arampatzis, A.S.; Kontogiannopoulos, K.N.; Theodoridis, K.; Aggelidou, E.; Rat, A.; Willems, A.; Tsivintzelis, I.; Papageorgiou, V.P.; Kritis, A.; Assimopoulou, A.N. Electrospun wound dressings containing bioactive natural products: Physico-chemical characterization and biological assessment. Biomater. Res. 2021, 25, 23. [Google Scholar] [CrossRef]
- Ma, K.; Qiu, Y.; Fu, Y.; Ni, Q.-Q. Improved shellac mediated nanoscale application drug release effect in a gastric-site drug delivery system. RSC Adv. 2017, 7, 53401–53406. [Google Scholar] [CrossRef]
- Yang, Y.; Chen, W.; Wang, M.; Shen, J.; Tang, Z.; Qin, Y.; Yu, D.-G. Engineered shellac beads-on-the-string fibers using triaxial electrospinning for improved colon-targeted drug delivery. Polymers 2023, 15, 2237. [Google Scholar] [CrossRef]
- Hosseini, S.M.; Abdouss, M.; Mazinani, S.; Soltanabadi, A.; Kalaee, M. Modified nanofiber containing chitosan and graphene oxide-magnetite nanoparticles as effective materials for smart wound dressing. Compos. B. Eng. 2022, 231, 109557. [Google Scholar] [CrossRef]
- Abali, S.O.; Ekenna, I.C. Comparison of the use of kinetic model plots and DD solver software to evaluate the drug release from griseofulvin tablets. J. Drug Deliv. Ther. 2022, 12, 5–13. [Google Scholar] [CrossRef]
- Mondal, A.; Sohel, M.A.; Mohammed, A.P.; Anu, A.S.; Thomas, S.; SenGupta, A. Crystallization study of shellac investigated by differential scanning calorimetry. Polym. Bull. 2019, 77, 5127–5143. [Google Scholar] [CrossRef]
- Saengsod, S.; Limmatvapirat, S.; Luangtana-anan, M. Optimum condition of conventional bleaching process for bleached shellac. J. Food Process Eng. 2019, 42, e13291. [Google Scholar] [CrossRef]
- Yan, G.; Cao, Z.; Devine, D.; Penning, M.; Gately, N.M. Physical properties of shellac material used for hot melt extrusion with potential application in the pharmaceutical industry. Polymers 2021, 13, 3723. [Google Scholar] [CrossRef]
- Adiana, M.A.; Mazura, M.P. Study on Senna alata and its different extracts by Fourier transform infrared spectroscopy and two-dimensional correlation infrared spectroscopy. J. Mol. Struct. 2011, 991, 84–91. [Google Scholar] [CrossRef]
- Vannuruswamy, G.; Rathna, G.V.N.; Gadgil, B.S.T.; Gadad, A.P. Blends of shellac as nanofiber formulations for wound healing. J. Bioact. Compat. Polym. 2015, 30, 472–489. [Google Scholar] [CrossRef]
- Ariyanta, H.A.; Roji, F.; Apriandanu, D.O.B. Electrochemical activity of glassy carbon electrode modified with ZnO nanoparticles prepared Via Senna alata L. leaf extract towards antiretroviral drug. Micro Nano Syst. Lett. 2022, 10, 5. [Google Scholar] [CrossRef]
- Ramakrishna, S.; Fujihara, K.; Teo, W.; Lim, T.; Ma, Z. An Introduction to Electrospinning and Nanofibers; World Scientific Publishing Co. Pte. Ltd.: Singapore, 2005. [Google Scholar]
- Xue, J.; Wu, T.; Dai, Y.; Xia, Y. Electrospinning and electrospun nanofibers: Methods, materials, and applications. Chem Rev. 2019, 119, 5298–5415. [Google Scholar] [CrossRef] [PubMed]
- Sener, A.G.; Altay, A.S.; Lokumcu, A.F. Effect of voltage on morphology of electrospun nanofibers. In Proceedings of the 2011 7th International Conference on Electrical and Electronics Engineering (ELECO), Bursa, Turkey, 1–4 December 2011. [Google Scholar]
- Chinatangkul, N.; Pengon, S.; Piriyaprasarth, S.; Limmatvapirat, C.; Limmatvapirat, S. Development of electrospun shellac and hydroxypropyl cellulose blended nanofibers for drug carrier application. Key Eng. Mater. 2020, 859, 239–243. [Google Scholar] [CrossRef]
- Thammachat, T.; Sriamornsak, P.; Luangtana-Anan, M.; Nunthanid, J.; Limmatvapirat, C.; Limmatvapirat, S. Preparation and characterization of shellac fiber as a novel material for controlled drug release. Adv. Mat. Res. 2010, 152–153, 1232–1235. [Google Scholar] [CrossRef]
- Motamedi, A.S.; Mirzadeh, H.; Hajiesmaeilbaigi, F.; Bagheri-Khoulenjani, S.; Shokrgozar, M. Effect of electrospinning parameters on morphological properties of PVDF nanofibrous scaffolds. Prog. Biomater. 2017, 6, 113–123. [Google Scholar] [CrossRef]
- Ozaytekin, I. The effect of carboxylic acid group on conductivity of the aromatic polyazomethines and char composites. Polym. Compos. 2014, 35, 372–380. [Google Scholar] [CrossRef]
- Sriyanti, I.; Edikresnha, D.; Rahma, A.; Munir, M.M.; Rachmawati, H.; Khairurrijal, K. Mangosteen pericarp extract embedded in electrospun PVP nanofiber mats: Physicochemical properties and release mechanism of alpha-mangostin. Int. J. Nanomed. 2018, 13, 4927–4941. [Google Scholar] [CrossRef] [PubMed]
- Böncü, T.E.; Ozdemir, N. Effects of drug concentration and PLGA addition on the properties of electrospun ampicillin trihydrate-loaded PLA nanofibers. Beilstein J. Nanotechnol. 2022, 13, 245–254. [Google Scholar] [CrossRef] [PubMed]
- Ravikumar, R.; Ganesh, M.; Senthil, V.; Ramesh, Y.V.; Jakki, S.L.; Choi, E.Y. Tetrahydro curcumin loaded PCL-PEG electrospun transdermal nanofiber patch: Preparation, characterization, and in vitro diffusion evaluations. J. Drug Deliv. Sci. Technol. 2018, 44, 342–348. [Google Scholar] [CrossRef]
- Jirofti, N.; Golandi, M.; Movaffagh, J.; Ahmadi, F.S.; Kalalinia, F. Improvement of the wound-healing process by curcumin-loaded chitosan/collagen blend electrospun nanofibers: In Vitro and in vivo studies. ACS Biomater. Sci. Eng. 2021, 7, 3886–3897. [Google Scholar] [CrossRef]
- Sun, X.Z.; Williams, G.R.; Hou, X.X.; Zhu, L.M. Electrospun curcumin-loaded fibers with potential biomedical applications. Carbohydr. Polym. 2013, 94, 147–153. [Google Scholar] [CrossRef] [PubMed]
- Wei, Z.; Liu, E.; Li, H.; Wei, Z.; Lv, Z. Release characteristics of different diameter ultrafine fibers as antibacterial materials. J. Innov. Opt. Health Sci. 2021, 14, 2041005. [Google Scholar] [CrossRef]
- Farag, Y.; Leopold, C.S. Physicochemical properties of various shellac types. Dissolution Technol. 2009, 16, 33–39. [Google Scholar] [CrossRef]
- Farag, Y.; Leopold, C.S. Development of shellac-coated sustained release pellet formulations. Eur. J. Pharm. Sci. 2011, 42, 400–405. [Google Scholar] [CrossRef]
- Gupta, R.; Chen, Y.; Sarkar, M.; Xie, H. Surfactant mediated accelerated and discriminatory in vitro drug release method for PLGA nanoparticles of poorly water-soluble drug. Pharmaceuticals 2022, 15, 1489. [Google Scholar] [CrossRef]
- Ye, P.; Wei, S.; Luo, C.; Wang, Q.; Li, A.; Wei, F. Long-term effect against methicillin-resistant Staphylococcus aureus of emodin released from coaxial electrospinning nanofiber membranes with a biphasic profile. Biomolecules 2020, 10, 362. [Google Scholar] [CrossRef] [PubMed]

| Independent Variables | Symbol | Level | ||
|---|---|---|---|---|
| Low (−1) | Center (0) | High (+1) | ||
| Shellac content (% w/w) | X1 | 35.00 | 40.00 | 45.00 |
| SA leaf extract content (% w/w) | X2 | 1.00 | 2.50 | 4.00 |
| Applied voltage (kV) | X3 | 9.00 | 18.00 | 27.00 |
| Feed rate (mL/h) | X4 | 0.40 | 0.80 | 1.20 |
| Needle tip diameter (mm) | X5 | 0.61 | 0.84 | 1.06 |
| Independent Variables | Symbol | Level | ||
|---|---|---|---|---|
| Low (−1) | Center (0) | High (+1) | ||
| Shellac content (% w/w) | X1 | 35.00 | 40.00 | 45.00 |
| SA leaf extract content (% w/w) | X2 | 1.00 | 2.50 | 4.00 |
| Applied voltage (kV) | X3 | 9.00 | 16.50 | 24.00 |
| Feed rate (mL/h) | X4 | 0.40 | 0.80 | 1.20 |
| Run | Independent Variables | Responses | |||||
|---|---|---|---|---|---|---|---|
| X1 Shellac Content (% w/w) | X2 Extract Content (% w/w) | X3 Applied Voltage (kV) | X4 Feed Rate (mL/h) | X5 Needle Tip Diameter (mm) | R1 Fiber Diameter (nm) | R2 Bead-To-Fiber Ratio | |
| 1 | −1 (35.00) | −1 (1.00) | 1 (27.00) | 1 (1.20) | 1 (1.06) | 401.02 ± 22.79 | 4.45 ± 1.30 |
| 2 | −1 (35.00) | −1 (1.00) | −1 (9.00) | 1 (1.20) | −1 (0.61) | 398.99 ± 3.71 | 5.27 ± 1.07 |
| 3 | 0 (40.00) | 0 (2.50) | 0 (18.00) | 0 (0.80) | 0 (0.84) | 360.93 ± 13.26 | 0.32 ± 0.11 |
| 4 | 1 (45.00) | −1 (1.00) | 1 (27.00) | 1 (1.20) | −1 (0.61) | 773.52 ± 25.61 | 0.17 ± 0.02 |
| 5 | 1 (45.00) | 1 (4.00) | 1 (27.00) | 1 (1.20) | 1 (1.06) | 749.96 ± 15.79 | 0.16 ± 0.12 |
| 6 | −1 (35.00) | 1 (4.00) | 1 (27.00) | −1 (0.40) | 1 (1.06) | 396.22 ± 10.62 | 0.56 ± 0.29 |
| 7 | −1 (35.00) | −1 (1.00) | 1 (27.00) | −1 (0.40) | −1 (0.61) | 368.51 ± 8.74 | 1.39 ± 0.61 |
| 8 | −1 (35.00) | 1 (4.00) | −1 (9.00) | −1 (0.40) | −1 (0.61) | 374.57 ± 9.27 | 1.43 ± 0.81 |
| 9 | 1 (45.00) | 1 (4.00) | −1 (9.00) | 1 (1.20) | −1 (0.61) | 394.49 ± 9.52 | 0.02 ± 0.01 |
| 10 | 1 (45.00) | −1 (1.00) | 1 (27.00) | −1 (0.40) | 1 (1.06) | 727.32 ± 4.43 | 0.17 ± 0.07 |
| 11 | −1 (35.00) | 1 (4.00) | 1 (27.00) | 1 (1.20) | −1 (0.61) | 330.31 ± 10.38 | 4.12 ± 0.68 |
| 12 | 1 (45.00) | 1 (4.00) | 1 (27.00) | −1 (0.40) | −1 (0.61) | 680.65 ± 8.98 | 0.28 ± 0.12 |
| 13 | −1 (35.00) | 1 (4.00) | −1 (9.00) | 1 (1.20) | 1 (1.06) | 343.44 ± 6.93 | 4.45 ± 1.47 |
| 14 | 1 (45.00) | 1 (4.00) | −1 (9.00) | −1 (0.40) | 1 (1.06) | 419.49 ± 3.24 | 0.02 ± 0.01 |
| 15 | 1 (45.00) | −1 (1.00) | −1 (9.00) | −1 (0.40) | −1 (0.61) | 425.40 ± 11.30 | 0.02 ± 0.01 |
| 16 | 0 (40.00) | 0 (2.50) | 0 (18.00) | 0 (0.80) | 0 (0.84) | 323.91 ± 7.84 | 0.34 ± 0.08 |
| 17 | −1 (35.00) | −1 (1.00) | −1 (9.00) | −1 (0.40) | 1 (1.06) | 387.38 ± 2.71 | 1.03 ± 0.26 |
| 18 | 1 (45.00) | −1 (1.00) | −1 (9.00) | 1 (1.20) | 1 (1.06) | 435.88 ± 5.41 | 0.02 ± 0.01 |
| 19 | 0 (40.00) | 0 (2.50) | 0 (18.00) | 0 (0.80) | 0 (0.84) | 349.50 ± 3.19 | 0.57 ± 0.14 |
| Source | Sum of Squares | df | Mean Square | F Value | p-Value Prob > F |
|---|---|---|---|---|---|
| Response 1—Fiber diameter | |||||
| Model | 359,000 | 3 | 120,000 | 32.97 | <0.0001 * |
| X1—Shellac content | 161,000 | 1 | 161,000 | 44.49 | <0.0001 * |
| X3—Applied voltage | 97,320.85 | 1 | 97,320.85 | 26.85 | 0.0001 * |
| X1X3 | 99,939.92 | 1 | 99,939.92 | 27.58 | <0.0001 * |
| Residual | 54,362.18 | 15 | 3624.15 | ||
| Lack of Fit | 53,643.40 | 13 | 4126.42 | 11.48 | 0.0829 ** |
| Pure Error | 718.78 | 2 | 359.39 | ||
| Cor Total | 413,000 | 18 | |||
| R2 = 0.8683 Adj R2 = 0.8420 Pred R2 = 0.8274 | |||||
| Response 2—Bead-to-fiber ratio | |||||
| Model | 53.90 | 3 | 17.97 | 64.62 | <0.0001 * |
| X1—Shellac content | 29.81 | 1 | 29.81 | 107.22 | <0.0001 * |
| X4—Feed rate | 11.83 | 1 | 11.83 | 42.56 | <0.0001 * |
| X1X4 | 12.25 | 1 | 12.25 | 44.06 | <0.0001 * |
| Residual | 4.17 | 15 | 0.28 | ||
| Lack of Fit | 4.13 | 13 | 0.32 | 16.47 | 0.0587 ** |
| Pure Error | 0.04 | 2 | 0.02 | ||
| Cor Total | 58.07 | 18 | |||
| R2 = 0.9282 Adj R2 = 0.9138 Pred R2 = 0.9016 | |||||
| Run | Independent Variables | Responses | |||||
|---|---|---|---|---|---|---|---|
| X1 Shellac Content (% w/w) | X2 Extract Content (% w/w) | X3 Applied Voltage (kV) | X4 Feed Rate (mL/h) | R1 Fiber Diameter (nm) | R2 Bead-to-Fiber Ratio | R3 Entrapment Efficiency (%) | |
| 1 | 0 (40.00) | 0 (2.50) | 0 (16.50) | 0 (0.80) | 343.99 ± 13.90 | 0.33 ± 0.02 | 82.33 |
| 2 | 0 (40.00) | 0 (2.50) | 1 (24.00) | −1 (0.40) | 335.26 ± 3.92 | 0.43 ± 0.05 | 96.04 |
| 3 | 1 (45.00) | 0 (2.50) | 1 (24.00) | 0 (0.80) | 446.89 ± 13.01 | 0.09 ± 0.08 | 77.44 |
| 4 | −1(35.00) | −1 (1.00) | 0 (16.50) | 0 (0.80) | 310.52 ± 29.01 | 2.37 ± 0.49 | 96.81 |
| 5 | 0 (40.00) | 0 (2.50) | 0 (16.50) | 0 (0.80) | 359.51 ± 5.93 | 0.46 ± 0.12 | 82.94 |
| 6 | 1 (45.00) | −1 (1.00) | 0 (16.50) | 0 (0.80) | 355.37 ± 10.94 | 0.05 ± 0.04 | 70.53 |
| 7 | 0 (40.00) | 0 (2.50) | 1 (24.00) | 1 (1.20) | 336.23 ± 20.90 | 0.16 ± 0.03 | 90.05 |
| 8 | −1(35.00) | 0 (2.50) | −1 (9.00) | 0 (0.80) | 325.04 ± 26.16 | 4.05 ± 0.23 | 102.99 |
| 9 | 0 (40.00) | 1 (4.00) | 1 (24.00) | 0 (0.80) | 351.06 ± 20.18 | 0.09 ± 0.01 | 95.52 |
| 10 | 1 (45.00) | 0 (2.50) | 0 (16.50) | 1 (1.20) | 414.27 ± 19.82 | 0.02 ± 0.01 | 68.97 |
| 11 | −1(35.00) | 0 (2.50) | 1 (24.00) | 0 (0.80) | 312.57 ± 8.51 | 1.47 ± 0.20 | 105.42 |
| 12 | −1(35.00) | 1 (4.00) | 0 (16.50) | 0 (0.80) | 280.29 ± 21.53 | 1.99 ± 0.65 | 77.55 |
| 13 | 1 (45.00) | 1 (4.00) | 0 (16.50) | 0 (0.80) | 422.24 ± 22.60 | 0.02 ± 0.01 | 66.39 |
| 14 | 0 (40.00) | 0 (2.50) | 0 (16.50) | 0 (0.80) | 319.79 ± 17.05 | 0.57 ± 0.11 | 83.54 |
| 15 | 0 (40.00) | 1 (4.00) | 0 (16.50) | −1 (0.40) | 276.04 ± 10.89 | 0.09 ± 0.04 | 76.70 |
| 16 | 1 (45.00) | 0 (2.50) | 0 (16.50) | −1 (0.40) | 390.48 ± 15.29 | 0.03 ± 0.01 | 58.88 |
| 17 | −1(35.00) | 0 (2.50) | 0 (16.50) | −1 (0.40) | 259.94 ± 23.12 | 2.13 ± 0.13 | 99.81 |
| 18 | 0 (40.00) | 0 (2.50) | −1 (9.00) | 1 (1.20) | 426.59 ± 11.20 | 1.65 ± 0.44 | 80.84 |
| 19 | 0 (40.00) | 1 (4.00) | 0 (16.50) | 1 (1.20) | 277.07 ± 10.24 | 0.07 ± 0.02 | 87.74 |
| 20 | 0 (40.00) | −1 (1.00) | 0 (16.50) | 1 (1.20) | 291.10 ± 7.12 | 0.34 ± 0.06 | 93.81 |
| 21 | 0 (40.00) | 0 (2.50) | 0 (16.50) | 0 (0.80) | 310.52 ± 2.16 | 0.39 ± 0.07 | 90.24 |
| 22 | 0 (40.00) | −1 (1.00) | 1 (24.00) | 0 (0.80) | 356.75 ± 23.34 | 0.22 ± 0.03 | 99.44 |
| 23 | 0 (40.00) | 1 (4.00) | −1 (9.00) | 0 (0.80) | 480.01 ± 8.57 | 1.16 ± 0.40 | 77.87 |
| 24 | 1 (45.00) | 0 (2.50) | −1 (9.00) | 0 (0.80) | 523.86 ± 6.69 | 0.25 ± 0.06 | 59.84 |
| 25 | −1(35.00) | 0 (2.50) | 0 (16.50) | 1 (1.20) | 226.20 ± 5.42 | 2.62 ± 0.97 | 88.39 |
| 26 | 0 (40.00) | 0 (2.50) | 0 (16.50) | 0 (0.80) | 318.21 ± 2.27 | 0.38 ± 0.10 | 82.19 |
| 27 | 0 (40.00) | 0 (2.50) | −1 (9.00) | −1 (0.40) | 462.28 ± 7.76 | 1.31 ± 0.47 | 74.99 |
| 28 | 0 (40.00) | −1 (1.00) | 0 (16.50) | −1 (0.40) | 332.74 ± 10.42 | 0.37 ± 0.12 | 85.82 |
| 29 | 0 (40.00) | −1 (1.00) | −1 (9.00) | 0 (0.80) | 410.33 ± 6.35 | 1.48 ± 0.69 | 95.13 |
| Source | Sum of Squares | df | Mean Square | F Value | p-Value Prob > F |
|---|---|---|---|---|---|
| Response 1—Fiber diameter | |||||
| Model | 118,000 | 3 | 39,162.78 | 43.96 | <0.0001 * |
| X1—Shellac content | 58,597.40 | 1 | 58,597.40 | 65.77 | <0.0001 * |
| X3—Voltage | 19,954.60 | 1 | 19,954.60 | 22.40 | <0.0001 * |
| X32 | 38,936.35 | 1 | 38,936.35 | 43.70 | <0.0001 * |
| Residual | 22,273.41 | 25 | 890.94 | ||
| Lack of Fit | 20,585.04 | 21 | 980.24 | 2.32 | 0.2151 *** |
| Pure Error | 1688.37 | 4 | 422.09 | ||
| Cor Total | 139,800 | 28 | |||
| R2 = 0.8406 Adj R2 = 0.8215 Pred R2 = 0.7835 | |||||
| Response 2—Bead-to-fiber ratio | |||||
| Model | 27.59 | 6 | 4.60 | 162.82 | <0.0001 * |
| X1—Shellac content | 16.73 | 1 | 16.73 | 592.40 | <0.0001 * |
| X2—Extract content | 0.17 | 1 | 0.17 | 5.87 | 0.0241 ** |
| X3—Voltage | 4.61 | 1 | 4.61 | 163.31 | <0.0001 * |
| X1X3 | 1.46 | 1 | 1.46 | 51.84 | <0.0001 * |
| X12 | 3.94 | 1 | 3.94 | 139.49 | <0.0001 * |
| X32 | 1.18 | 1 | 1.18 | 41.94 | <0.0001 * |
| Residual | 0.62 | 22 | 0.03 | ||
| Lack of Fit | 0.59 | 18 | 0.03 | 3.78 | 0.1032 *** |
| Pure Error | 0.03 | 4 | 8.63 × 10−3 | ||
| Cor Total | 28.21 | 28 | |||
| R2 = 0.9780 Adj R2 = 0.9720 Pred R2 = 0.9546 | |||||
| Response 3—Entrapment efficiency | |||||
| Model | 3537.04 | 5 | 707.41 | 21.82 | <0.0001 * |
| X1—Shellac content | 2377.95 | 1 | 2377.95 | 73.34 | <0.0001 * |
| X2—Extract content | 297.57 | 1 | 297.57 | 9.18 | 0.0060 * |
| X3—Voltage | 434.97 | 1 | 434.97 | 13.42 | 0.0013 * |
| X12 | 169.60 | 1 | 169.60 | 5.23 | 0.0317 ** |
| X32 | 198.54 | 1 | 198.54 | 6.12 | 0.0211 ** |
| Residual | 745.75 | 23 | 32.42 | ||
| Lack of Fit | 699.71 | 19 | 36.83 | 3.20 | 0.1340 *** |
| Pure Error | 46.04 | 4 | 11.51 | ||
| Cor Total | 4282.80 | 28 | |||
| R2 = 0.8259 Adj R2 = 0.7880 Pred R2 = 0.7052 | |||||
| Name | Goal | Lower Limit | Upper Limit |
|---|---|---|---|
| X1: Shellac content (% w/w) | in range | 35.00 | 45.00 |
| X2: Extract content (% w/w) | in range | 1.00 | 4.00 |
| X3: Applied voltage (kV) | in range | 9.00 | 24.00 |
| X4: Feed rate (mL/h) | equal to 0.8 mL/h | 0.40 | 1.20 |
| Fiber diameter (nm) | in range | 250 | 500 |
| Bead-to-fiber ratio | in range | 0.02 | 0.30 |
| Entrapment efficiency (%) | in range | 95.00 | 105.00 |
| No | Applied Voltage (kV) | Feed Rate (mL/h) | Shellac Content (% w/w) | Extract Content (% w/w) | Fiber Diameter (nm) | Bead-to-Fiber Ratio | Entrapment Efficiency (%) | Desirability |
|---|---|---|---|---|---|---|---|---|
| 1 | 23.99 | 0.80 | 38.50 | 3.80 | 335.36 | 0.30 | 95.07 | 1.00 |
| Response | Prediction | Experimental Value | 95% PI Low | 95% PI High |
|---|---|---|---|---|
| Fiber diameter | 335.36 | 305.77 ± 10.93 | 291.59 | 379.13 |
| Bead-to-fiber ratio | 0.30 | 0.29 ± 0.05 | 0.02 | 0.57 |
| Entrapment efficiency | 95.07 | 96.38 ± 1.42 | 86.11 | 104.03 |
| Shellac Content (% w/w) | SA leaf Extract Content (% w/w) | Viscosity (mPa · S) (Mean ± SD) | Conductivity (µS) (Mean ± SD) | Surface Tension (mN/m) (Mean ± SD) |
|---|---|---|---|---|
| 35.00 | 0.00 | 30.81 ± 1.74 | 94.17 ± 0.15 | 28.15 ± 0.15 |
| 40.00 | 0.00 | 59.49 ± 0.98 | 77.27 ± 0.31 | 28.56 ± 0.23 |
| 45.00 | 0.00 | 132.85 ± 1.22 | 71.50 ± 1.39 | 28.94 ± 0.06 |
| 35.00 | 1.00 | 35.89 ± 0.61 | 170.80 ± 3.36 | 27.64 ± 0.31 |
| 35.00 | 2.50 | 48.18 ± 2.82 | 178.50 ± 0.10 | 28.52 ± 0.08 |
| 35.00 | 4.00 | 52.71 ± 1.29 | 187.80 ± 1.01 | 30.23 ± 0.28 |
| 40.00 | 1.00 | 73.57 ± 1.22 | 160.10 ± 0.10 | 28.24 ± 0.16 |
| 40.00 | 2.50 | 91.89 ± 2.09 | 165.47 ± 1.29 | 28.64 ± 0.07 |
| 40.00 | 4.00 | 108.96 ± 4.36 | 179.17 ± 0.74 | 29.08 ± 0.05 |
| 45.00 | 1.00 | 159.41 ± 3.81 | 158.00 ± 0.56 | 30.60 ± 0.11 |
| 45.00 | 2.50 | 183.61 ± 1.42 | 160.40 ± 0.10 | 30.32 ± 0.09 |
| 45.00 | 4.00 | 267.98 ± 6.94 | 176.50 ± 1.18 | 32.05 ± 0.19 |
| 38.50 (Optimized) | 3.80 (Optimized) | 88.36 ± 3.15 | 180.20 ± 0.66 | 29.11 ± 0.09 |
Disclaimer/Publisher’s Note: The statements, opinions and data contained in all publications are solely those of the individual author(s) and contributor(s) and not of MDPI and/or the editor(s). MDPI and/or the editor(s) disclaim responsibility for any injury to people or property resulting from any ideas, methods, instructions or products referred to in the content. |
© 2024 by the authors. Licensee MDPI, Basel, Switzerland. This article is an open access article distributed under the terms and conditions of the Creative Commons Attribution (CC BY) license (https://creativecommons.org/licenses/by/4.0/).
Share and Cite
Aung, W.W.; Krongrawa, W.; Limmatvapirat, S.; Kulpicheswanich, P.; Okonogi, S.; Limmatvapirat, C. Fabrication and Optimization of Electrospun Shellac Fibers Loaded with Senna alata Leaf Extract. Polymers 2024, 16, 183. https://doi.org/10.3390/polym16020183
Aung WW, Krongrawa W, Limmatvapirat S, Kulpicheswanich P, Okonogi S, Limmatvapirat C. Fabrication and Optimization of Electrospun Shellac Fibers Loaded with Senna alata Leaf Extract. Polymers. 2024; 16(2):183. https://doi.org/10.3390/polym16020183
Chicago/Turabian StyleAung, Wah Wah, Wantanwa Krongrawa, Sontaya Limmatvapirat, Pattranit Kulpicheswanich, Siriporn Okonogi, and Chutima Limmatvapirat. 2024. "Fabrication and Optimization of Electrospun Shellac Fibers Loaded with Senna alata Leaf Extract" Polymers 16, no. 2: 183. https://doi.org/10.3390/polym16020183
APA StyleAung, W. W., Krongrawa, W., Limmatvapirat, S., Kulpicheswanich, P., Okonogi, S., & Limmatvapirat, C. (2024). Fabrication and Optimization of Electrospun Shellac Fibers Loaded with Senna alata Leaf Extract. Polymers, 16(2), 183. https://doi.org/10.3390/polym16020183

